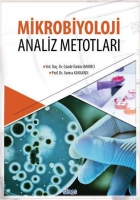

Sıralama
Tüm Kategoriler
- Bücher
- Aile Kitaplığı
- Başvuru - Kaynak
- Bilişim - Elektronik
- Çocuk Kitapları
- Din
- Edebiyat
- Eğitim
- Ekonomi
- Etnik
- Felsefe - Düşünce
- Hobi
- Hukuk
- İletişim - Medya
- İslam
- Kişisel Gelişim
- Müzik
- Psikoloji
- Sanat - Mimarlık
- Sınavlara Hazırlık
- Siyaset
- Sosyoloji
- Spor
- Tarih
- Temel Bilimler - Mühendislik
- Tıp - Sağlık
- Turizm - Gezi
- Yemek Kitapları
- Sesli Kitap / Sesli Kitaplar
- Musik
- Arabesk
- Rap & HipHop
- Türkçe Jazz (Caz) & Blues
- Halk Müziği
- Fantazi & Nostalji
- Türkçe Pop
- Türkçe Rock
- Film & Dizi Müzikleri
- Klasik Müzik
- Çocuklar & Aile İçin
- Oyun Havaları - Oriental
- Enstrumantal
- Diğer
- Dini Yayın
- Şiir & Anlatı
- Dans
- Kürtçe
- Etnik
- New Age
- Alternatif
- Elektro - Sufi - Chill Out
- Özgün Musik
- Tango Kanto Operet
- Karadeniz
- Alaturka
- Relax & Chill-Out
- İlahiler
- Filme
- Elektro-Küchengeräte
- Çubuk Blender Setleri
- Mikserler
- Mutfak Robotları
- Tost Makineleri
- Ekmek Kızartma Makineleri
- Elektrikli Pişiriciler
- Fritözler
- Mikrodalgalar
- Mini Fırınlar
- Mısır Patlama Makineleri
- Doğrayıcılar
- Katı Meyve Setleri
- Narenciye Sıkacakları
- Düdüklü Tencereler
- Seramik Tava
- Seramik Tencere
- Seramik Sahan
- Seramik Buharlı
- Elektro-Haushaltsgeräte
- Tee- u. Kaffeemaschinen
- Babypflege
- Heimtextilien
Kategori
Gözde Türköz Bakırcı, Yaşar Hışıl - Kitap
2 sonuç bulundu
24,99 EUR
23,99 EUR
19,99 EUR
18,99 EUR